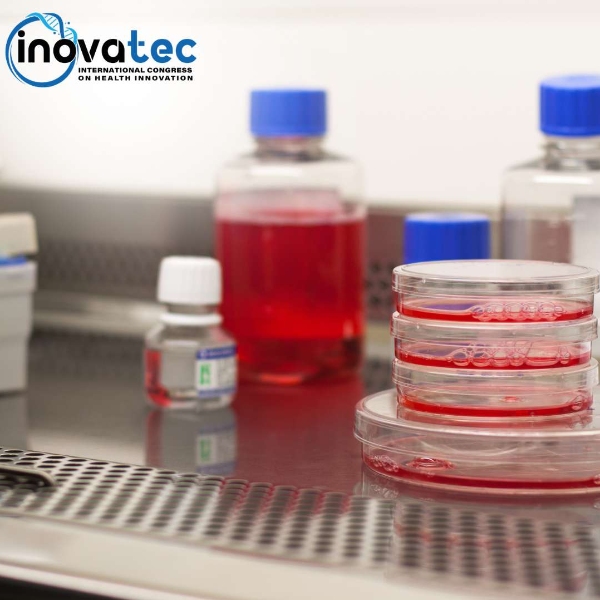

Os minicursos pré-congresso são treinamentos e capacitações técnico-científicos em temas relevantes a estudantes e profissionais da Saúde e de áreas transversais.
Os minicursos são presenciais e serão realizados ao longo de todo o ano 2026 em diferentes locais e horários, por isso atenção à data, local e horários para evitar realizar inscrição em cursos simultâneos.
Todos conferem certificados e as vagas são limitadas.
Maiores informações em: https://inovatecdf.com.br/index.php/minicursos/
Inscrições

IV Curso de técnicas histológicas: da teoria à prática clínica
Minicurso

Cicatrização inteligente: Inovações em curativos e cuidados com feridas
Minicurso

Boas práticas de pipetagem e manuseio de líquidos
Minicurso
Tópicos essenciais em cultura de células 3D: Teoria e prática
Minicurso

VI Curso Teórico-Prático em Cromatografia Líquida de Alta Eficiência (CLAE) e Tópicos Especiais de Espectrometria de Massas
Minicurso

Planejamento e estratégias de sucesso na captação de recursos para inovação
Minicurso
Campus Darcy Ribeiro
Asa Norte, Brasília - DF
70900-000
Por favor, descreva abaixo a razão da sua denúncia.
People&Science Pesquisa Desenvolvimento e Inovação LTDA é uma empresa brasiliense sediada no Centro de Apoio ao Desenvolvimento Tecnológico da Universidade de Brasília (CDT-UnB) e tem como atividade principal a pesquisa e desenvolvimento de soluções altamente qualificadas baseadas em Ciência e Tecnologia nas áreas de HealthTech e AgroTech. Desde o início de suas atividades vem promovendo eventos científicos, cursos e treinamentos para qualificação de recursos humanos.